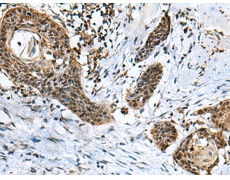
一抗

中文名稱: 兔抗GLI1多克隆抗體
|
Background: |
This gene encodes a member of the Kruppel family of zinc finger proteins. The encoded transcription factor is activated by the sonic hedgehog signal transduction cascade and regulates stem cell proliferation. The activity and nuclear localization of this protein is negatively regulated by p53 in an inhibitory loop. Multiple transcript variants encoding different isoforms have been found for this gene. |
|
Applications: |
ELISA, WB, IHC |
|
Name of antibody: |
GLI1 |
|
Immunogen: |
Synthetic peptide of human GLI1 |
|
Full name: |
GLI family zinc finger 1 |
|
Synonyms: |
GLI |
|
SwissProt: |
P08151 |
|
ELISA Recommended dilution: |
5000-10000 |
|
IHC positive control: |
Human esophagus cancer |
|
IHC Recommend dilution: |
50-100 |
|
WB Predicted band size: |
118 kDa |
|
WB Positive control: |
Raji and HepG2 cell lysates |
|
WB Recommended dilution: |
500-2000 |


 購物車
購物車 幫助
幫助
 021-54845833/15800441009
021-54845833/15800441009